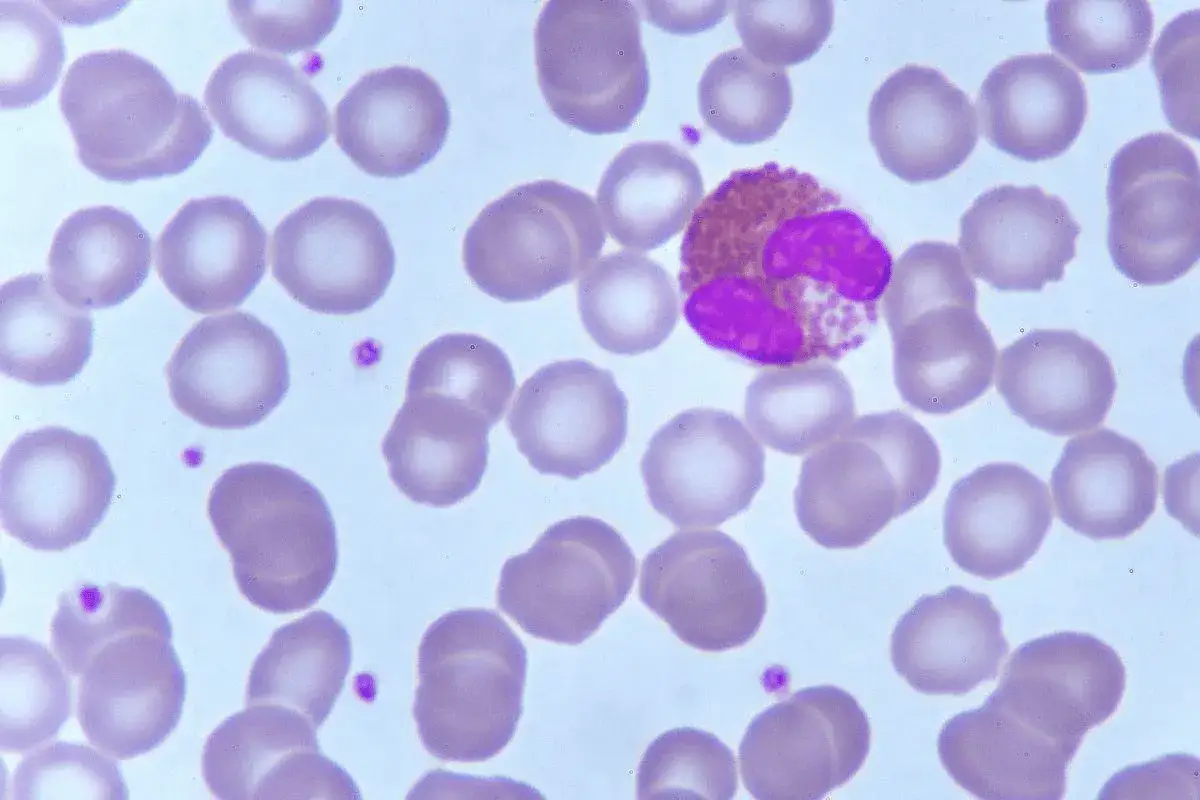
Mikroskopowy obraz krwi: widoczne liczne erytrocyty i jeden granulocyt obojętnochłonny z dwoma jądrami, sugerujący eozynofile podwyższone.

Twoje wyniki badań krwi wskazują na podwyższony poziom eozynofili, co naturalnie budzi pytania i obawy. Ten artykuł pomoże Ci zrozumieć, czym są eozynofile, jakie mogą być przyczyny ich podwyższonego poziomu oraz jakie kroki należy podjąć, aby zadbać o swoje zdrowie.
Podwyższone eozynofile – co oznaczają dla Twojego zdrowia
- Eozynofile to białe krwinki kluczowe dla odporności, szczególnie w walce z pasożytami i reakcjach alergicznych.
- Norma u dorosłych wynosi zazwyczaj 50-500 komórek/µl (1-6% leukocytów), a przekroczenie tej wartości to eozynofilia.
- Najczęstsze przyczyny podwyższonych eozynofili to alergie, infekcje pasożytnicze, choroby autoimmunologiczne, reakcje polekowe i niektóre nowotwory.
- Objawy towarzyszące eozynofilii są zróżnicowane i zależą od jej podstawowej przyczyny.
- Podwyższony poziom eozynofili zawsze wymaga konsultacji z lekarzem w celu ustalenia dokładnej diagnozy i wdrożenia odpowiedniego leczenia.
- Leczenie eozynofilii polega na wyeliminowaniu lub kontrolowaniu jej pierwotnej przyczyny.
Dostałeś wyniki krwi i martwią Cię podwyższone eozynofile? Wyjaśniamy, co to oznacza
Otrzymanie wyników badań, które odbiegają od normy, zawsze może budzić niepokój. Jeśli zauważyłeś, że masz podwyższone eozynofile, pamiętaj, że jest to dość częsty wynik i nie zawsze świadczy o poważnej chorobie. To raczej sygnał, który wymaga dalszej analizy i zrozumienia, co dzieje się w Twoim organizmie. Pozwól, że przeprowadzę Cię przez ten temat, wyjaśniając krok po kroku, co mogą oznaczać te wartości i jakie działania warto podjąć.
EOS w morfologii – czym są eozynofile i jaką rolę pełnią w Twoim ciele?
Eozynofile, znane również jako granulocyty kwasochłonne (w skrócie EOS), to jeden z rodzajów białych krwinek, czyli leukocytów. Stanowią one ważny element Twojego układu odpornościowego, pełniąc kluczowe funkcje obronne. Ich podstawową rolą jest walka z infekcjami pasożytniczymi – eozynofile są szczególnie skuteczne w niszczeniu larw i dorosłych form pasożytów. Ponadto, odgrywają znaczącą rolę w reakcjach alergicznych, gdzie ich obecność i aktywność często prowadzi do wystąpienia charakterystycznych objawów.
Jak czytać wyniki? Normy dla eozynofili u dorosłych i dzieci
Stan, w którym liczba eozynofili we krwi przekracza prawidłowe wartości, nazywamy eozynofilią. Aby prawidłowo zinterpretować swoje wyniki, warto znać normy. U dorosłych, norma eozynofili wynosi zazwyczaj od 50 do 500 komórek na mikrolitr (µl), co stanowi około 1-6% wszystkich leukocytów. Ważne jest, aby pamiętać, że te wartości mogą się nieznacznie różnić w zależności od laboratorium, dlatego zawsze należy odnosić się do zakresów referencyjnych podanych na Twoich wynikach.
W przypadku dzieci, normy eozynofili mogą być nieco inne. Często w młodszych grupach wiekowych dopuszczalne są nieco wyższe wartości, co jest związane z intensywnym rozwojem układu odpornościowego i częstszym kontaktem z różnymi patogenami i alergenami w środowisku. Poniżej przedstawiam stopnie eozynofilii, które pomogą Ci zorientować się w skali problemu, jeśli Twoje wyniki odbiegają od normy:
| Stopień eozynofilii | Liczba komórek/µl |
|---|---|
| Łagodna | 500 – 1500 |
| Umiarkowana | 1500 – 5000 |
| Ciężka | powyżej 5000 |
Podwyższone eozynofile – czy to zawsze powód do niepokoju?
Podwyższone eozynofile to sygnał, który zawsze wymaga uwagi, ale nie zawsze jest powodem do paniki. Wiele osób, widząc takie wyniki, od razu myśli o najgorszym, jednak w rzeczywistości większość przyczyn eozynofilii jest łatwych do zdiagnozowania i skutecznego leczenia. Często stoją za nimi stosunkowo łagodne schorzenia, takie jak alergie sezonowe czy infekcje pasożytnicze, które po odpowiedniej terapii ustępują, a poziom eozynofili wraca do normy.Kluczowe jest jednak to, aby nie ignorować tego sygnału. Podwyższone eozynofile to informacja, że Twój układ odpornościowy aktywnie walczy z czymś w organizmie. Tylko lekarz, po zebraniu szczegółowego wywiadu, analizie wszystkich wyników badań i ocenie Twojego ogólnego stanu zdrowia, jest w stanie prawidłowo zinterpretować te dane i wskazać dalszą ścieżkę diagnostyczną lub terapeutyczną. Nie próbuj stawiać diagnozy na własną rękę, ale potraktuj to jako motywację do wizyty u specjalisty.

Od alergii po infekcje – poznaj 7 najczęstszych przyczyn eozynofilii
Podwyższony poziom eozynofili może mieć wiele źródeł, od stosunkowo łagodnych, które są łatwe do opanowania, po te, które wymagają bardziej szczegółowej diagnostyki i specjalistycznego leczenia. Zrozumienie potencjalnych przyczyn jest pierwszym krokiem do ustalenia, co dzieje się w Twoim ciele. Poniżej omówię najczęstsze z nich, abyś mógł lepiej zrozumieć kontekst swoich wyników.
Alergie i astma: Dlaczego Twój układ odpornościowy jest w stanie gotowości?
Jedną z najczęstszych przyczyn podwyższonych eozynofili są choroby alergiczne. Kiedy Twój organizm ma kontakt z alergenem (np. pyłkami, roztoczami, sierścią zwierząt, niektórymi pokarmami), układ odpornościowy reaguje nadmiernie, traktując nieszkodliwą substancję jako zagrożenie. Eozynofile odgrywają kluczową rolę w tej reakcji, uwalniając substancje chemiczne, które prowadzą do stanu zapalnego i typowych objawów alergii. Przykładami schorzeń, w których obserwuje się wzrost eozynofili, są astma oskrzelowa, alergiczny nieżyt nosa, atopowe zapalenie skóry (AZS) czy alergie pokarmowe.
Niewidzialni wrogowie: Jak pasożyty wpływają na poziom eozynofili?
Infekcje pasożytnicze to kolejna bardzo częsta przyczyna eozynofilii, zwłaszcza w regionach o niższych standardach higienicznych lub po podróżach zagranicznych. Eozynofile są wyspecjalizowane w walce z pasożytami, takimi jak nicienie czy tasiemce. Kiedy pasożyt dostaje się do organizmu, eozynofile są mobilizowane do miejsca infekcji, gdzie próbują go zniszczyć. Przykłady zakażeń, które mogą prowadzić do wzrostu eozynofili, to glista ludzka, owsica (szczególnie powszechna u dzieci), tasiemiec czy toksokaroza. Wzrost eozynofili w tym przypadku jest naturalną odpowiedzią obronną organizmu.
Gdy organizm atakuje sam siebie: Rola eozynofilii w chorobach autoimmunologicznych
Eozynofilia może również towarzyszyć niektórym chorobom autoimmunologicznym. W tych schorzeniach układ odpornościowy, zamiast chronić organizm przed zewnętrznymi zagrożeniami, błędnie atakuje własne tkanki i narządy. Eozynofile, choć nie są głównymi komórkami odpowiedzialnymi za autoagresję, mogą być zaangażowane w złożoną reakcję zapalną, która jest charakterystyczna dla tych chorób. Przykłady to reumatoidalne zapalenie stawów, toczeń rumieniowaty układowy czy nieswoiste choroby zapalne jelit.
Choroby skóry, o których mogą świadczyć wyniki: Atopowe zapalenie skóry i inne dermatozy
W kontekście chorób skóry, atopowe zapalenie skóry (AZS) jest jednym z najczęstszych schorzeń, w którym obserwuje się podwyższony poziom eozynofili. AZS to przewlekła choroba zapalna skóry o podłożu alergicznym, charakteryzująca się suchością, świądem i zmianami wypryskowymi. Eozynofile biorą udział w patogenezie AZS, przyczyniając się do stanu zapalnego i uszkodzenia bariery skórnej. Oprócz AZS, istnieją również inne, rzadsze dermatozy eozynofilowe, takie jak eozynofilowe zapalenie tkanki łącznej (zespół Shulmana) czy pęcherzyca eozynofilowa, gdzie eozynofile są głównymi komórkami zapalnymi, prowadzącymi do charakterystycznych zmian skórnych.
Czy leki mogą fałszować wyniki? Które preparaty podnoszą eozynofile?
Czasami podwyższony poziom eozynofili może być wynikiem reakcji polekowej. Niektóre leki mogą wywoływać w organizmie reakcję nadwrażliwości, która objawia się wzrostem liczby tych komórek. Jest to zazwyczaj przejściowa odpowiedź układu odpornościowego. Do grup leków, które mogą prowadzić do eozynofilii, należą między innymi niektóre antybiotyki (np. penicyliny, cefalosporyny), leki przeciwzapalne (NLPZ), a także leki przeciwpadaczkowe. Jeśli przyjmujesz jakiekolwiek leki i masz podwyższone eozynofile, koniecznie poinformuj o tym swojego lekarza – to bardzo ważna informacja diagnostyczna.
Eozynofilia a nowotwory: Kiedy podwyższone EOS to sygnał alarmowy?
Warto wspomnieć, że w rzadkich przypadkach eozynofilia może być związana z chorobami nowotworowymi. Niektóre nowotwory, zwłaszcza hematologiczne, takie jak przewlekła białaczka eozynofilowa (gdzie eozynofile są bezpośrednio zaangażowane w proces chorobowy) czy niektóre chłoniaki (np. chłoniak Hodgkina), mogą prowadzić do znacznego wzrostu eozynofili. Chociaż jest to jedna z rzadszych przyczyn, zwłaszcza w porównaniu z alergiami czy pasożytami, w przypadku utrzymującej się, niewyjaśnionej eozynofilii, lekarz może zlecić dalszą diagnostykę onkologiczną. Pamiętaj jednak, że to scenariusz mniej prawdopodobny, a lekarz zawsze będzie dążył do wykluczenia najczęstszych przyczyn w pierwszej kolejności.
Inne, rzadsze przyczyny: Choroby płuc, jelit i zaburzenia hormonalne
Poza wymienionymi, istnieje szereg innych, rzadszych schorzeń, które mogą prowadzić do podwyższonego poziomu eozynofili. Należą do nich na przykład eozynofilowe zapalenie płuc, które charakteryzuje się naciekami eozynofilowymi w płucach i może objawiać się kaszlem, dusznością i gorączką. Podobnie, eozynofilowe zapalenie jelit, w którym eozynofile gromadzą się w ścianie przewodu pokarmowego, może powodować bóle brzucha, nudności, wymioty i biegunkę. Warto również wspomnieć o możliwym związku z niektórymi zaburzeniami hormonalnymi, takimi jak niedoczynność kory nadnerczy (choroba Addisona), choć są to przypadki rzadkie i wymagające specyficznej diagnostyki endokrynologicznej. Jak widać, spektrum przyczyn jest szerokie, co podkreśla znaczenie kompleksowej oceny medycznej.

Jakie objawy powinny zwrócić Twoją uwagę, gdy eozynofile są podwyższone?
Podwyższone eozynofile same w sobie rzadko dają specyficzne objawy. To raczej wskaźnik, który kieruje uwagę lekarza na potencjalne problemy. Objawy, które mogą towarzyszyć eozynofilii, są zazwyczaj niespecyficzne i zawsze zależą od jej podstawowej przyczyny. Dlatego tak ważne jest, abyś uważnie obserwował swoje ciało i zgłaszał lekarzowi wszelkie niepokojące symptomy, nawet te, które wydają się nieistotne. To pomoże w szybszym i trafniejszym postawieniu diagnozy.
Symptomy skórne i oddechowe – typowe objawy przy alergiach
Jeśli przyczyną podwyższonych eozynofili jest alergia, objawy często koncentrują się na układzie oddechowym i skórze. Możesz doświadczać kataru, kichania, zatkanego nosa, kaszlu, a nawet duszności, zwłaszcza jeśli cierpisz na astmę. Na skórze mogą pojawić się wysypki, świąd, pokrzywka lub zaostrzenie zmian w przypadku atopowego zapalenia skóry. Te objawy często mają charakter sezonowy (np. alergia na pyłki) lub są związane z ekspozycją na konkretny alergen, co może pomóc w identyfikacji problemu.
Problemy żołądkowo-jelitowe – sygnał infekcji pasożytniczej?
W przypadku infekcji pasożytniczych lub eozynofilowych chorób przewodu pokarmowego, objawy często dotyczą układu pokarmowego. Mogą to być bóle brzucha, biegunki, nudności, wymioty, a także utrata apetytu lub niezamierzona utrata wagi. Niekiedy mogą pojawić się również wzdęcia czy uczucie dyskomfortu po jedzeniu. Takie symptomy, zwłaszcza jeśli utrzymują się przez dłuższy czas, powinny skłonić do diagnostyki w kierunku obecności pasożytów.
Objawy ogólnoustrojowe: Zmęczenie, gorączka i utrata wagi przy ciężkiej eozynofilii
Przy bardzo wysokim poziomie eozynofili, czyli w przypadku ciężkiej eozynofilii, mogą pojawić się objawy ogólnoustrojowe, wskazujące na potencjalne uszkodzenie narządów. Należą do nich przewlekłe zmęczenie, niewyjaśniona gorączka, niezamierzona utrata masy ciała, a także bóle mięśni i stawów. Te symptomy są alarmujące i zawsze wymagają pilnej konsultacji lekarskiej, ponieważ mogą świadczyć o poważniejszych schorzeniach, takich jak choroby autoimmunologiczne czy nowotworowe, wymagające natychmiastowej interwencji medycznej.

Podwyższone eozynofile w wynikach – co robić krok po kroku?
Otrzymanie wyników badań z podwyższonymi eozynofilami może być stresujące, ale najważniejsze jest zachowanie spokoju i podjęcie systematycznych działań. Pamiętaj, że masz wpływ na swoje zdrowie, a odpowiednie kroki diagnostyczne i terapeutyczne mogą szybko przynieść ulgę i wyjaśnić przyczynę problemu.
Spokojna analiza sytuacji: Kiedy wystarczy obserwacja, a kiedy iść do lekarza?
Przede wszystkim, nie panikuj. Jednorazowy, niewielki wzrost eozynofili, zwłaszcza bez towarzyszących objawów, może być przejściowy i nie zawsze świadczy o poważnej chorobie. Czasem może być wynikiem niedawnej, łagodnej infekcji wirusowej, która już ustępuje, lub krótkotrwałego kontaktu z alergenem. Jeśli jednak podwyższone wartości utrzymują się w kolejnych badaniach, a zwłaszcza gdy towarzyszą im niepokojące objawy, zawsze należy skonsultować się z lekarzem. Tylko specjalista jest w stanie ocenić Twoje wyniki w kontekście ogólnego stanu zdrowia, historii medycznej i wszystkich innych czynników, które mogą mieć wpływ na diagnozę.
Jak przygotować się do wizyty u lekarza? Informacje, które warto zebrać
Aby wizyta u lekarza była jak najbardziej efektywna i przyspieszyła proces diagnostyczny, warto się do niej odpowiednio przygotować. Oto lista informacji, które mogą okazać się niezwykle pomocne:
- Daty i wyniki poprzednich badań krwi: Jeśli masz wcześniejsze wyniki morfologii, zabierz je ze sobą. Pozwolą one lekarzowi ocenić dynamikę zmian.
- Wszelkie objawy: Zapisz wszystkie objawy, które zauważyłeś, nawet te pozornie niezwiązane z podwyższonymi eozynofilami. Określ, kiedy się pojawiły, jak często występują i jakie jest ich nasilenie.
- Lista przyjmowanych leków: Przygotuj listę wszystkich leków, suplementów diety i ziół, które aktualnie przyjmujesz lub przyjmowałeś w ostatnim czasie.
- Historia alergii: Poinformuj o wszelkich alergiach u siebie lub w rodzinie.
- Informacje o podróżach zagranicznych: Jeśli w ostatnim czasie podróżowałeś, zwłaszcza do krajów tropikalnych, koniecznie o tym wspomnij.
- Zmiany w diecie lub stylu życia: Czy ostatnio coś znacząco zmieniło się w Twojej diecie, otoczeniu lub nawykach?
- Występowanie chorób przewlekłych: Poinformuj lekarza o wszystkich chorobach przewlekłych, na które cierpisz.
Diagnostyka eozynofilii: Jakie badania zleci lekarz, aby znaleźć przyczynę?
Diagnostyka podwyższonych eozynofili to proces etapowy. Lekarz, po zebraniu wywiadu i wstępnej ocenie, dobierze odpowiednie badania, które pomogą ustalić pierwotną przyczynę problemu. Nie ma jednego uniwersalnego zestawu testów – wszystko zależy od indywidualnej sytuacji pacjenta i podejrzeń klinicznych.
Morfologia krwi z rozmazem – co jeszcze można z niej wyczytać?
Morfologia krwi z rozmazem jest pierwszym i podstawowym badaniem, które dostarcza informacji o liczbie eozynofili. Jednak to nie wszystko, co można z niej wyczytać. Lekarz dokładnie oceni także inne parametry krwi, takie jak poziom hemoglobiny (który może wskazywać na anemię), liczbę innych leukocytów (neutrofili, limfocytów, monocytów), a także płytek krwi. Nieprawidłowości w tych parametrach mogą dostarczyć cennych wskazówek diagnostycznych, na przykład sugerować infekcję bakteryjną, wirusową lub inne schorzenia, które mogą współistnieć z eozynofilią.
W poszukiwaniu alergii: Rola testów skórnych i badania poziomu IgE
Jeśli lekarz podejrzewa podłoże alergiczne, zleci odpowiednie badania w kierunku alergii. Najczęściej są to testy skórne punktowe, które polegają na nałożeniu na skórę niewielkich ilości alergenów i obserwacji reakcji. Inną metodą jest badanie krwi, które pozwala oznaczyć poziom IgE całkowitego (przeciwciał odpowiedzialnych za reakcje alergiczne) oraz IgE specyficznego dla konkretnych alergenów. Te testy pomagają zidentyfikować, na co dokładnie Twój organizm reaguje alergicznie, co jest kluczowe dla dalszego leczenia.
Badanie kału i inne testy – jak potwierdzić lub wykluczyć pasożyty?
W przypadku podejrzenia infekcji pasożytniczej, podstawowym badaniem jest badanie kału na obecność pasożytów i ich jaj. Często konieczne jest kilkukrotne powtórzenie tego badania, ponieważ pasożyty wydalają jaja cyklicznie. W niektórych sytuacjach, zwłaszcza gdy podejrzewa się konkretne typy pasożytów, które nie są łatwe do wykrycia w kale, lekarz może zlecić również badania serologiczne. Polegają one na wykrywaniu w krwi przeciwciał skierowanych przeciwko antygenom pasożytów, co może potwierdzić ich obecność w organizmie.
Diagnostyka obrazowa i specjalistyczna – kiedy jest potrzebna?
W niektórych przypadkach, zwłaszcza gdy wstępne badania nie dają jednoznacznej odpowiedzi lub gdy eozynofilia jest bardzo wysoka i utrzymuje się, lekarz może zlecić bardziej zaawansowane testy. Mogą to być badania oceniające markery stanu zapalnego, takie jak OB (odczyn Biernackiego) i CRP (białko C-reaktywne), a także badania oceniające funkcję wątroby i nerek, aby wykluczyć ich uszkodzenie. W przypadku podejrzenia eozynofilii narządowej (np. w płucach, jelitach) lub nowotworowej, konieczne mogą być badania obrazowe (np. RTG klatki piersiowej, USG jamy brzusznej, tomografia komputerowa) lub bardziej inwazyjne procedury, takie jak endoskopia z pobraniem biopsji czy biopsja szpiku kostnego. Te badania są wykonywane w celu dokładnego zlokalizowania problemu i postawienia precyzyjnej diagnozy.
Jak wygląda leczenie i czy można obniżyć poziom eozynofili?
Dobra wiadomość jest taka, że w większości przypadków podwyższony poziom eozynofili można skutecznie obniżyć. Kluczem do sukcesu jest jednak prawidłowe zdiagnozowanie i leczenie pierwotnej przyczyny. Bez usunięcia źródła problemu, eozynofile prawdopodobnie pozostaną podwyższone.
Leczenie przyczynowe: Klucz do normalizacji wyników
Leczenie eozynofilii zawsze koncentruje się na wyeliminowaniu lub kontrolowaniu jej podstawowej przyczyny. Oznacza to, że terapia będzie wyglądać zupełnie inaczej w zależności od tego, co wywołało wzrost eozynofili. Na przykład, w przypadku alergii, lekarz może zalecić stosowanie leków przeciwhistaminowych, glikokortykosteroidów (miejscowo lub ogólnie) lub immunoterapii swoistej (odczulanie). Jeśli przyczyną są pasożyty, wdrożone zostanie leczenie przeciwpasożytnicze. W chorobach autoimmunologicznych konieczna będzie specyficzna terapia immunosupresyjna, a w przypadku nowotworów – leczenie onkologiczne. Po skutecznym leczeniu pierwotnej choroby, poziom eozynofili zazwyczaj wraca do normy, co jest dobrym wskaźnikiem poprawy stanu zdrowia.
Przeczytaj również: Biopsja skóry - czy to boli? Pełny przewodnik dla pacjenta
Zmiany w diecie i stylu życia, które mogą wspomóc terapię
Poza leczeniem farmakologicznym, pewne zmiany w diecie i stylu życia mogą znacząco wspomóc proces leczenia i ogólną kondycję organizmu, zwłaszcza jeśli podwyższone eozynofile są związane z alergiami czy problemami jelitowymi:
- Unikanie zidentyfikowanych alergenów pokarmowych: Jeśli testy wykazały alergię na konkretne produkty, ich eliminacja z diety jest kluczowa.
- Wprowadzenie zbilansowanej diety: Dieta bogata w warzywa, owoce, pełnoziarniste produkty i zdrowe tłuszcze wspiera układ odpornościowy i ogólne zdrowie.
- Dbanie o higienę: Regularne mycie rąk, zwłaszcza przed posiłkami i po kontakcie ze zwierzętami, jest ważne w profilaktyce infekcji pasożytniczych.
- Unikanie stresu: Przewlekły stres może osłabiać układ odpornościowy i zaostrzać objawy wielu chorób. Techniki relaksacyjne mogą być pomocne.
- Regularna aktywność fizyczna: Jeśli stan zdrowia na to pozwala, umiarkowana aktywność fizyczna poprawia krążenie, wzmacnia odporność i ogólne samopoczucie.
- Odpowiednia ilość snu: Regenerujący sen jest niezbędny dla prawidłowego funkcjonowania układu odpornościowego i procesów naprawczych w organizmie.
